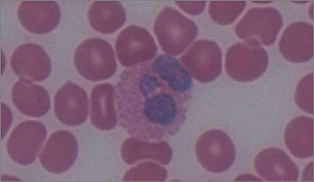

Recuento de leucocitos
Fórmula leucocitaria |
Frotis y Tinción |
Tipos de leucocitos |
Alteraciones |
Glosario
|
Células sanguíneas
Podemos agrupar los elementos formes o figurados de la sangre en los siguientes tres grupos:
- Glóbulos blancos o leucocitos:
Células blancas de la sangre. Nucleadas y con distintas morfologías tras su tinción.
Incluyen los siguientes tipos celulares:
- Granulocitos o leucocitos con gran cantidad de gránulos en su citoplasma y que a su vez son
polimorfonucleares, ya que tienen un núcleo compuesto por varios lóbulos, de forma que adquiere
formas poco regulares: neutrófilos, eosinófilos y basófilos.
- Agranulocitos o células comparativamente con pocos gránulos en su citoplasma y que a su vez son
mononucleares, ya que tienen un núcleo simple: monocitos, linfocitos y macrófagos (estos derivan
de los monocitos pero se localizan en los tejidos).
- Glóbulos rojos, hematíes o eritrocitos
Elementos anucleados de la sangre y que por lo tanto no son células propiamente dichas (han perdido el núcleo así
como muchos orgánulos citoplásmicos). Tienen unos 7 µm de diámetro, forma cóncava y un aspecto rosado tras una
tinción Giemsa. Dan el color rojo a la sangre por poseer hemoglobina. Su principal función es el transporte de
oxígeno a los tejidos. Constituye el elemento principal en sangre: en hombres 5,4 millones/µl; en mujeres
4,5 millones/µl; rango normal medio es 4-6 x 106/µl (de 500-1000 por cada leucocito).
- Plaquetas o trombocitos
Fragmentos citoplásmicos de 2 a 3 µm derivados de los megacariocitos. Se tiñen de color azulado oscuro con la
tinción de Giemsa. Al agregarse permiten la coagulación de la sangre.
Los leucocitos o células blancas de la sangre son fácilmente reconocibles en un frotis ya que son
células nucleadas (a diferencia de las plaquetas y los hematíes). Estas células se originan en la
médula ósea y se relacionan con la protección del organismo frente a diversos ataques a su integridad,
como pueden ser las infecciones.
El recuento de leucocitos (células blancas de la sangre) o WBC (White Blood Cells Count) es una parte
del recuento total de células sanguíneas (CBC o Complete Blood Cell Count) y consiste en el recuento de
leucocitos en un pequeño volumen sanguíneo. Este análisis puede ser microscópico, o lo que es más habitual hoy
en día, se pueden utilizar analizadores hematológicos automáticos que permiten la diferenciación y cuantificación
de los distintos tipos de células sanguíneas en base a su tamaño y complejidad (en relación a las características
de sus citoplasmas y núcleos).
El recuento total de leucocitos o formula leucocitaria
Representa la cantidad de
cada uno de los tipos de leucocitos en sangre periférica. Se puede expresar como valor ABSOLUTO de
cada tipo de leucocito por mm3 de sangre o como valor RELATIVO que hace referencia al porcentaje de
cada tipo de leucocitos presentes en la muestra sanguínea respecto al total. Los valores relativos
de diversos tipos celulares pueden verse alterados de forma indirecta porque se ha visto alterada
otra de las poblaciones celulares sanguíneas. Alteraciones en el recuento de alguna de las
poblaciones en concreto o de más de una de ellas suele ir ligado a diversas anomalías o
problemáticas de diversa índole. De esta forma el recuento de leucocitos puede tener una
gran importancia clínica ya que se pueden evaluar ciertos parámetros de relevancia en cuanto
al estado, respuesta y evolución del organismo en el caso de infecciones, inflamación, alergias,
cáncer, inmunodéficits, terapias, etc. Para evitar interpretar los resultados de forma indebida
las alteraciones cuantitativas se deben referir siempre en términos absolutos.
Los rangos de referencia para un recuento de leucocitos en adultos son los siguientes:
| Tipo celular |
Rango de valores (células/µl) |
Valor medio (células/µl) |
% normal |
% medio |
Tamaño (µm) |
| Leucocitos | 4000-11000 | 7400 | | | 7-18 |
|
Granulocitos/ polimorfonucleares | Neutrófilo | 2500-7500 | 4000 | 50-70 | 60 | 12-15 |
| Eosinófilo | 40-400 | 200 | 1-4 | 3 | 12-15 |
| Basófilo | 10-100 | 40 | 0,2-1 | 1 | 8-12 |
|
Agranulocitos/ mononucleares | Linfocito | 1500-3500 | 2500 | 20-40 | 32 | 7-12 |
| Monocito | 200-800 | 300 | 2-8 | 4 | 12-18 |
Los valores normales de leucocitos pueden diferir considerablemente entre distintas poblaciones,
sexos y estados especiales como el embarazo.
En sangre se pueden observar también neutrófilos inmaduros liberados por la médula ósea
antes de terminar su maduración de nominados neutrófilos en cayado
(por la forma de su núcleo aun sin lóbulos definidos y con forma de bastón grueso) y
pueden aparecer en un 1-5 % (100-150 cayados/µl).
| |
|
Preparación de un frotis sanguíneo
Introducción
Un frotis de sangre o frotis sanguíneo es una fina capa de sangre extendida sobre un portaobjetos
y teñida de tal forma que permite realizar un estudio microscópico de los diversos tipos de células
sanguíneas,
La realización y observación de frotis sanguíneos es una de las técnicas más ampliamente
utilizadas a nivel mundial en los laboratorios de screening, diagnóstico y monitorización
de enfermedades. Con el frotis se obtiene información sobre el número y la morfología de
los elementos visibles en la sangre lo que pueden ser indicativo de diversas alteraciones
o enfermedades, como por ejemplo entre otros, en casos de leucemias, deficiencias de hierro,
trastornos genéticos de la forma de los eritrocitos o posibles deficiencias de vitamina B12.
Mediante el frotis podemos obtener información útil en relación a:
- La diferenciación y recuento de los elementos formes de la sangre.
- Las alteraciones singulares en la forma de las células, que son una identificación específica de algunas enfermedades.
- Algún indicador de los efectos nocivos de la quimioterapia y de la radioterapia.
La fidelidad de la información obtenida del frotis, depende en gran parte de la calidad de la extensión.
Por ello, y para obtener buenos resultados hay que tener en cuenta los siguientes aspectos:
- Tanto portaobjetos como cubreobjetos deben estar bien limpios y desengrasados (preferentemente nuevos).
- Para realizar la extensión el portaobjetos debe estar bien nivelado.
- La sangre no debe haber estado en contacto con anticoagulantes, pues éstos podrían deformar la morfología celular.
- La gota de sangre utilizada para la preparación del frotis ha de obtenerse por punción capilar y no debe ser muy grande, ni muy pequeña (preferentemente del tamaño de la cabeza de un alfiler, ~ 3 mm). Si la extensión es demasiado gruesa las células se pueden amontonar y no ser reconocidas, ni diferenciadas. Si la extensión es demasiado delgada las células se pueden deformar, distorsionar y destruir.
- La lectura del frotis debe hacerse en aquellas zonas donde los eritrocitos "casi se tocan".
Preparación del frotis sanguíneo
Conviene hacer todo el procedimiento sobre una superficie fija y sujetando los portas como se indica en el dibujo.
- Colocar un portaobjetos bien limpio en una superficie lisa y bien nivelada.
- Con una lanceta estéril realizar una punción en un dedo.
- Depositar una gota de sangre de 3 a 4 mm de diámetro a unos 2 o 3 cm de uno de los extremos del portaobjetos porta totalmente limpio (libre de pelusas y grasa).
- Con el borde de otro portaobjetos bien limpio tocar la gota de sangre. Dicha gota se extiende por capilaridad a lo largo del canto de este último portaobjetos. (el porta para extender la gota de sangre no debe ser nunca mas ancho que el portaobjetos que tiene la sangre ya que de lo contrario puede haber efectos indeseados en cuanto a la distribución de las células en la muestra.
- Con un movimiento rápido y uniforme y manteniendo un ángulo de 30-45 grados entre ambos portaobjetos, y procurando no perder el contacto entre ambos portas, extender la gota de sangre arrastrando un porta sobre el otro, Debe quedar una capa fina de sangre en la superficie del primer porta.
- Esperar a que se seque la lámina, dejarla sobre una rejilla o toalla de papel, con la zona donde está la muestra mirando hacia arriba.
- Dejar secar al aire (solo si el grado de humedad es muy alto se recomienda el secado forzado con secador).
Fijación del frotis
Se obtienen resultados óptimos cuando la muestra se fija con metanol después de secarla
(preferiblemente antes de 1 h) y antes de teñirla. En caso contrario puede que el plasma haga
que aparezca un fondo grisáceo/azulado no deseado. Para fijar y teñir las preparaciones
conviene que las soluciones de fijado y las de tinción estén lo mas libres de agua posible (<3%).
Cuando se utilizan colorantes hematológicos habituales, la fijación se realiza durante
la aplicación del colorante concentrado, ya que lleva metanol absoluto como disolvente.
Cuando se va a trabajar con colorantes acuosos diluidos, los frotis secados al aire deben
ser fijados en metanol absoluto durante unos minutos (1-5 min).
Tinción del frotis sanguíneo
El análisis sanguíneo al microscopio requiere preparar un frotis con sangre del paciente y
teñir la muestra con Giemsa u otra tinción similar de forma que cada tipo celular adquiere una coloración
y aspectos característicos que ayuden a su detección e identificación.
Los colorantes ácidos de estas tinciones se unen a componentes básicos de las células (citoplasma),
mientras que los colorantes básicos son atraídos por los componentes ácidos (núcleo), de forma que se pueden
distinguir los distintos tipos de células sanguíneas.
Eosinófilo |
 Neutrófilo |
 Linfocito |
 Monocito |
| |
|
Carasterísticas de cada tipo de leucocitos
El análisis sanguíneo al microscopio habitualmente se realiza tras hacer una tinción de Giemsa
o similar de forma que cada tipo celular adquiere una coloración y aspectos característicos
que ayudan a su detección e identificación en el examen microscópico.
Los lecucitos presentes en el frotis corresponderán a alguno de los tipos descritos en la siguiente tabla:
| Leucocito |
Características |
Asociación |
Granulocitos/Polimorfonucleares
|
| Neutrófilo |
Núcleo multilobulado (2 a 5 lóbulos) e irregular. Citoplasma con pequeños gránulos rosáceos
(algunos gránulos de color azul-violáceo y lisosomas de color púrpura-rojizo).
|
Infecciones agudas |
| Eosinófilo |
Algo más grande que los neutrófilos. Núcleo bilobulado y grandes gránulos rojo-fucsia-naranja en su citoplasma.
|
Reacciones alérgicas y parasitarias |
| Basófilo |
En muy baja concentración en la sangre, tiene un núcleo de forma irregular (normalmente bilobulado)
y difícil de ver por los grandes gránulos citoplásmicos azul oscuro/marronáceos.
|
Reacciones alérgicas |
Agranulocitos/Mononucleares
|
| Linfocito |
Aunque incluye distintos tipos, fenotípicamente no se diferencian por microscopía óptica.
Tiene un núcleo muy denso, redondeado y azulado, que ocupa casi todo el citoplasma.
Citoplasma escaso/moderado, ocasionalmente con gránulos. Los más pequeños (de tamaño
ligeramente mayor a un eritrocito) son células inactivas y los linfocitos más grandes
suelen ser células activadas.
|
Infección crónica |
| Monocito |
Son los leucocitos de mayor tamaño. Núcleo simple más o menos invaginado (de ovalado
a forma de alubia, riñón, herradura). Citoplasma grisáceo-azulado que puede tener
algunas vacuolas y lisosomas de color púrpura-rojizo.
|
Infección crónica |
|
| Formas intermedias, no maduras, atípicas, etc. |
Infecciones, terapias, cáncer, etc.
|
| |
|
Alteraciones en las proporciones de leucocitos
Puede haber alteraciones numéricas y/o morfológicas.
En este apartado nos centraremos en las alteraciones númericas, que han sido resumidas en la seguiente tabla:
Alteraciones numéricas
| Leucocitosis |
- Neutrofilia
- Eosinifilia
- Basofilia
- Linfocitosis
- Monocitosis
|
|
Leucopenias |
- Neutropenia
- Eosinopenia
- Basopenia
- Linfocitopenia
- Monocitopenia
|
|
LEUCOCITOSIS
Incremento del número de leucocitos en sangre, con recuentos absolutos superiores a 11000 leucocitos/µl.
Se produce en respuesta a infección, estrés, alteraciones infamatorias u otras alteraciones como leucemia
(mieloides o linfocíticas). Puede deberse a un único elemento que aparece en elevadas cantidades o a una
combinación de elementos que aumentan su número, según cuál sea la causa.
En función de cual sea el elemento mayoritario que origina la leucocitosis se distinguen:
- Granulocitosis: Incremento del número de granulocitos en sangre.
- Neutrofilia (leucocitosis neutrofílica)
Incremento del número de neutrófilos en sangre con recuentos absolutos superiores a > 7500 neutrófilos/µl.
Causas: infecciones bacterianas agudas, daños tisulares independientes de infecciones.
- Eosinofilia (leucocitosis eosinofílica)
Incremento del número de eosinófilos en sangre con recuentos absolutos superiores a 400 eosinófilos/µl.
Los valores normales de eosinófilos son del 1 al 3 % de las células sanguíneas. En función del recuento
la eosinofília puede ser de varios tipos: débil cuando hay 500-1500 eosinófilos/µl; moderada con 1500-5000
eosinófilos/ l y severa > 5000 eosinófilos/µl.
Causas: alergia y otras reacciones de hipersensibilidad (por ejemplo provocadas por medicamentos)
e infecciones parasitarias.
- Basofilia (leucocitosis basofílica)
Incremento del número de basófilos en sangre con recuentos absolutos superiores a >100 basófilos/µl.
Causas: algunas reacciones alérgicas anómalas mediadas por IgE.
- Linfocitosis (leucocitosis linfocítica)
Incremento del número de linfocitos en sangre con recuentos absolutos superiores a 3500-4000 linfocitos/µl
(en adultos > 4000 linfocitos/µl y en niños >9000 linfocitos/µl). Habitualmente va
acompañada de monocitosis.
Causas: infecciones víricas (por ejemplo hepatitis, CMV o virus de Epstein-Barr) o bacterianas
(por ejemplo Bordetella).
- Monocitosis
Incremento del número de monocitos en sangre con recuentos absolutos superiores a 800 monocitos/µl
(o > 6 % del total de leucocitos).
Causas: infecciones crónicas (como tuberculosis o malaria), enfermedades inflamatorias, etc.
LEUCOPENIA
Disminución del número de leucocitos en sangre, con recuentos absolutos inferiores a 4000 leucocitos/µl.
Principalmente debida a un bajo número de neutrófilos (neutropenia).
Se produce por consumo de leucocitos tras una infección, por tratamientos que destruyen células como
la quimioterapia o la radioterapia o por alteraciones en las células madre de la médula ósea
(por ejemplo leucemia).
En función del tipo o tipos celulares problemáticos se distinguen varias situaciones:
- Granulocitopenia o agranulocitosis
Disminución del número de granulocitos (basófilos, eosinófilos y/o neutrófilos) en sangre.
La principal consecuencia de este problema es la tendencia a sufrir infecciones.
A menudo sinónimo de neutropenia.
- Neutropenia
Disminución del número de neutrófilos en sangre con recuentos absolutos inferiores a 1500
neutrófilos/µl. Es la leucopenia más frecuente. Existen diversos grados de neutropenia
siendo muy grave cuando el recuento absoluto es inferior a 200 neutrófilos/µl.
La principal consecuencia de este déficit es una mayor tendencia a las infecciones.
A menudo se utiliza como sinónimo de granulocitopenia.
- Eosinopenia
Disminución del número de eosinófilos en sangre. Resulta un problema poco común.
Se produce en diversas infecciones (neumonía, gripe,...) o situaciones de estrés, infarto,
tratamientos concretos,...
- Basopenia
Disminución del número de basófilos en sangre. Sinónimo de basocitopenia.
Se produce en algunas infecciones (brucelosis,...), patologías (hipertiroidismo,...) y diversas terapias.
- Linfopenia
Disminución del número de linfocitos en sangre, con recuentos absolutos inferiores a 1000 linfocitos/µl.
Habitualmente es relativa y debida a un aumento de neutrófilos. La linfopenia absoluta es signo de mal
pronóstico, en especial en infecciones graves.
Sinónimo de linfocitopenia y de leucopenia linfocítica.
- Monocitopenia
Disminución del número de monocitos en sangre, con recuentos absolutos inferiores a 200 monocitos/µl.
Se produce en infecciones agudas, leucemias agudas y diversas terapias (corticosteroides, citostáticos, etc).
Sinónimo de monopenia y de leucopenia monocítica.
| |
|
Glosario
- Agranulocito
Célula con pocos gránulos en el citoplasma. Incluyen linfocitos, monocitos y macrófagos
(estos últimos derivan de los monocitos sanguíneos y se localizan en los tejidos).
- Agranulocitosis
Disminución del número de granulocitos en sangre. Sinónimo de agranulosis, granulopenia y
granulocitopenia. A menudo sinónimo de neutropenia.
- Anemia
Disminución del número de eritrocitos en sangre.
- Basofilia
Incremento del número de basófilos en sangre con recuentos absolutos superiores a > 100 basófilos/µl.
Causas: algunas reacciones alérgicas anómalas mediadas por IgE.
Sinónimo de leucocitosis basofílica.
- Basófilo
Célula sanguínea, un tipo de leucocito: Aparece en muy baja concentración en la sangre, tiene
un núcleo de forma irregular (normalmente bilobulado) y difícil de ver por los grandes gránulos
citoplásmicos azul oscuro/marronáceos.
- Basopenia
Disminución del número de basófilos en sangre. Sinónimo de basocitopenia.
Se produce en algunas infecciones (brucelosis,...), patologías (hipertiroidismo,...) y diversas terapias.
- Eosinofília
Incremento del número de eosinófilos en sangre con recuentos absolutos superiores a 400 eosinófilos/µl.
Los valores normales de eosinófilos son del 1 al 3 % de las células sanguíneas. En función del recuento la eosinofília
puede ser de varios tipos: débil cuando hay 500-1500 eosinófilos/µl; moderada con 1500-5000 eosinófilos/µl
y severa > 5000 eosinófilos/µl.
Causas: alergia y otras reacciones de hipersensibilidad (por ejemplo provocadas por medicamentos) e infecciones
parasitarias.
Sinónimo de leucocitosis eosinofílica.
- Eosinófilo
Célula sanguínea, un tipo de leucocito. Algo más grande que los neutrófilos. Núcleo bilobulado y grandes
gránulos rojo-fucsia-naranja en su citoplasma.
- Eosinopenia
Disminución del número de eosinófilos en sangre. Resulta un problema poco común.
Se produce en diversas infecciones (neumonía, gripe,...) o situaciones de estrés, infarto,
tratamientos concretos,...
- Eritrocito
Elementos anucleados de la sangre y por lo tanto que ya no son células propiamente dichas
(han perdido el núcleo así como muchos orgánulos citoplásmicos). Tienen unos 7 µm de diámetro,
forma cóncava y un aspecto rosado tras una tinción Giemsa. Dan el color rojo a la sangre por poseer hemoglobina.
Su principal función es el transporte de oxígeno a los tejidos. Constituye el elemento principal en sangre:
en hombres 5,4 millones/µl; en mujeres 4,5 millones /µl;
rango normal medio es 4-6 x106/µl (de 500-1000 por cada leucocito).
- Glóbulo blanco
Ver leucocito.
- Glóbulo rojo
Ver eritrocito.
- Granulocito
Leucocitos con gran cantidad de gránulos en su citoplasma: basófilos, eosinófilos y neutrófilos.
- Granulocitopenia
Disminución del número de granulocitos (basófilos, eosinófilos y/o neutrófilos) en sangre.
La principal consecuencia de este problema es la tendencia a sufrir infecciones.
Sinónimo de agranulocitosis. A menudo equivalente a neutropenia.
- Granulocitosis
Incremento del número de granulocitos en sangre.
- Hematíe
Ver eritrocito.
- Leucemia
Cáncer sanguíneo o de médula ósea causado por glóbulos blancos atípicos.
Conjunto de cánceres de médula ósea que producen un elevado número de leucocitos.
- Leucocito
Células blanca de la sangre, fácilmente reconocible en un frotis ya que es nucleada
(a diferencia de plaquetas y hematíes). Se origina en la médula ósea y cuya función principal es combatir
las infecciones.
Realmente los leucocitos constituyen un grupo celular sanguíneo heterogéneo formado por distintos
tipo de células con diferente tamaño y fenotipo: basófilos, eosinófilos, neutrófilos, linfocitos y monocitos.
- Leucocitosis
Incremento del número de leucocitos en sangre, con recuentos absolutos superiores a 11000 leucocitos/µl.
Se produce en respuesta a infección, estrés, alteraciones infamatorias u otras alteraciones como leucemia (
mieloides o linfocíticas). Puede deberse a un único elemento que aparece en elevadas cantidades o a una combinación
de elementos que aumentan su número, según cuál sea la causa.
- Leucopenia
Disminución del número de leucocitos en sangre, con recuentos absolutos inferiores a 4000 leucocitos/µl.
Principalmente debida a un bajo número de neutrófilos (neutropenia).
Se produce por consumo de leucocitos tras una infección, por tratamientos que destruyen células como la
quimioterapia o la radioterapia o por alteraciones en las células madre de la médula ósea (por ejemplo leucemia).
- Linfocito
Célula sanguínea, un tipo de leucocito. Aunque incluyen distintos tipos, fenotípicamente no se diferencian por
microscopía óptica. Tienen un núcleo muy denso, redondeado y azulado, que ocupa casi todo el citoplasma.
Citoplasma escaso/moderado, ocasionalmente con gránulos. Los más pequeños (de tamaño ligeramente mayor a un eritrocito)
son células inactivas y los linfocitos más grandes suelen ser células activadas.
- Linfocitopenia
Ver linfopenia.
- Linfocitosis
Incremento del número de linfocitos en sangre con recuentos absolutos superiores a
3500-4000 linfocitos/µl (en adultos > 4000 linfocitos/µl y en niños > 9000 linfocitos/µl).
Habitualmente va acompañada de monocitosis.
Causas: infecciones víricas (por ejemplo hepatitis, CMV o virus de Epstein-Barr) o bacterianas
(por ejemplo Bordetella).
Sinónimo de leucocitosis linfocítica.
- Linfoma
Cáncer sanguíneo causado por linfocitos atípicos (habitualmente aparecen en cantidades elevadas).
- Linfopenia
Disminución del número de linfocitos en sangre, con recuentos absolutos inferiores a 1000
linfocitos/µl. Habitualmente es relativa y debida a un aumento de neutrófilos. La linfopenia absoluta
es signo de mal pronóstico, en especial en infecciones graves.
Sinónimo de linfopenia, linfocitopenia y de leucopenia linfocítica.
- Mieloma
Cáncer sanguíneo producido por células plasmáticas.
- Monocito
Célula sanguínea, los leucocitos de mayor tamaño. Núcleo simple más o menos invaginado
(de ovalado a forma de alubia, riñón, herradura). Citoplasma grisáceo-azulado que puede tener algunas vacuolas
y lisosomas de color púrpura-rojizo.
- Monocitopenia
Disminución del número de monocitos en sangre, con recuentos absolutos inferiores a 200 monocitos/µl.
Se produce en infecciones agudas, leucemias agudas y diversas terapias (corticosteroides, citostáticos, etc).
Sinónimo de monopenia y de leucopenia monocítica.
- Monocitosis
Incremento del número de monocitos en sangre con recuentos absolutos superiores a 800 monocitos/µ
l (o > 6 % del total de leucocitos).
Causas: infecciones crónicas (como tuberculosis o malaria), enfermedades inflamatorias, etc.
- Mononuclear
Célula sanguínea que tiene un núcleo simple: monocito, linfocito y macrófago (este deriva de los
monocitos pero se localiza en los tejidos).
- Neutrofilia
Incremento del número de neutrófilos en sangre con recuentos absolutos superiores a > 7500 neutrófilos/µl.
Causas: infecciones bacterianas agudas, daños tisulares independientes de infecciones.
Sinónimo de leucocitosis neutrofílica.
- Neutrófilo
Célula sanguínea, un tipo de leucocito. Núcleo multilobulado (3 a 5 lóbulos) e irregular.
Citoplasma con pequeños gránulos rosáceos (algunos gránulos de color azul-violáceo y lisosomas de color
púrpura-rojizo).
- Neutropenia
Disminución del número de neutrófilos en sangre con recuentos absolutos inferiores a 1500 neutrófilos/µl.
Es la leucopenia más frecuente. Existen diversos grados de neutropenia siendo muy grave cuando el recuento
absoluto es inferior a 200 neutrófilos/µl.
La principal consecuencia de este déficit es una mayor tendencia a las infecciones.
A menudo se utiliza como sinónimo de granulocitopenia.
- Pancitopenia
Disminución del número de glóbulos rojos, glóbulos blancos y plaquetas en sangre.
- Plaqueta
Elemento forme acelular sanguíneo. Fragmento citoplásmico de 2-3 µm derivado de los megacariocitos.
Se tiñen de color azulado oscuro con la tinción de Giemsa. Al agregarse permiten la coagulación de la sangre.
- Plasma
Fracción líquida y acelular de la sangre: suero + elementos coaguladores (fibrinógeno y factores II, V y VII).
Se obtienen tras centrifugar o dejar sedimentar sangre tratada con anticoagulantes.
No tienen células pero si proteínas, hormonas, desechos, etc.
- Policitemia
Incremento del número de eritrocitos en sangre.
- Polimorfonuclear
Célula sanguínea que tiene un núcleo compuesto por varios lóbulos, de forma que adquiere formas poco regulares:
neutrófilo, eosinófilo y basófilo.
- Suero
Fracción líquida de la sangre sin elementos coaguladores (fibrinógeno y factores II, V y VII).
Si no se trata la sangre con anticoagulantes, en unos minutos la sangre coagula y a partir de ésta
se obtiene el suero.
- Tronbocito
Ver plaqueta.
- Tronbocitopenia
Disminución del número de plaquetas en sangre.
< 100.000-150.000 plaquetas/µl.
- Tronbocitosis
Incremento del número de plaquetas en sangre.
> 400.000-750.000 plaquetas/µl.
- Tronbopenia
Ver tronbocitopenia.
| |
EJERCICIO NÚMERO 53320168 Mostrar otro problema
A partir de la muestra de sangre de sangre de un paciente se ha preparado un frotis
que ha sido teñido con Giemsa.
La figura de abajo representa lo que se vería en el microscopio.
El recuento de los distintos tipos celulares permitirá calcular la fórmula leucocitaria.
Resolución del ejercicio: Contar los distintos tipos de leucocitos y rellenar el formulario que se adjunta a la imagen.
En base a los resultados, identificar el término que describe el estado del paciente (pueden ser uno o dos términos).
Por último, para comprobar los resultados hacer click sobre el enlace. El sistema indicará si la respuesta es correcta o no.
NOTA: La imagen mostrada es artificial y esta preparada para que las alteraciones se detecten
en base a los porcentajes de los diferentes tipos celulares (valores relativos), si bien sería más adecuado
considerar el número de células por unidad de volumen (valores absolutos).
|